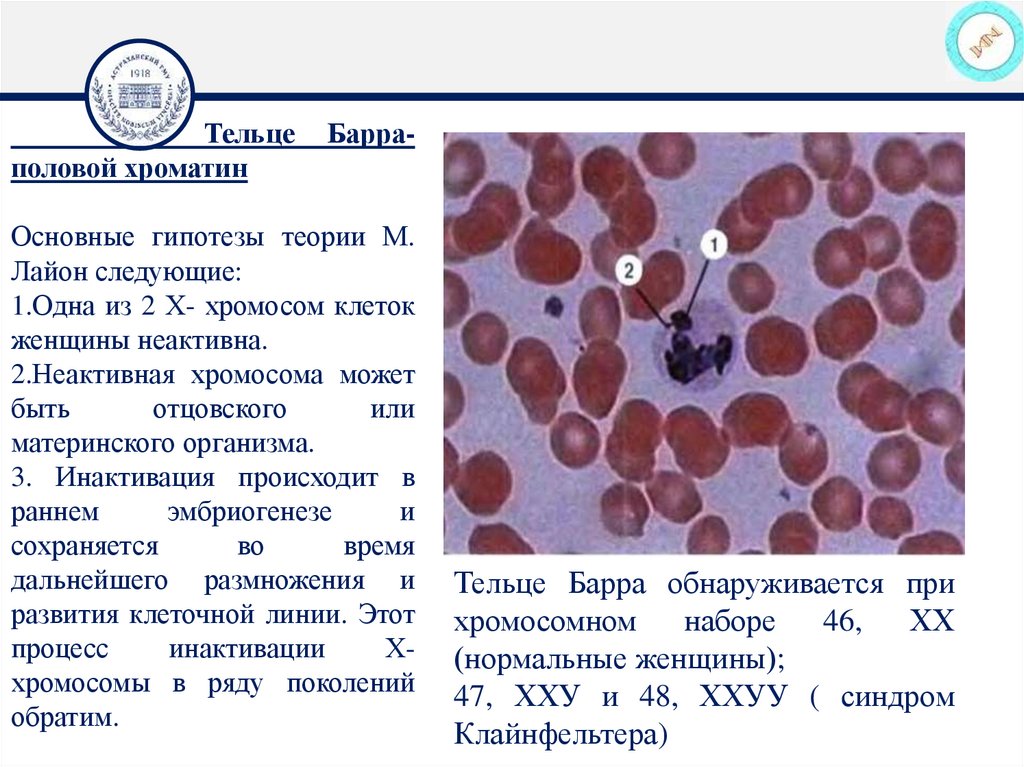

Похожие презентации:
Структурные уровни наследственного материала. Современные представления о строении хромосом. Типы и группы хромосом человека
1. Федеральное государственное бюджетное образовательное учреждение высшего образования «Астраханский государственный медицинский
университет» Министерства Здравоохранения РоссийскойФедерации
Кафедра биологии и ботаники
2. Введение
• В начале ХХ века была неопровержимо доказана рольхромосом как основных носителей наследственного
материала в эукариотической клетке. Подтверждение
этому было получено при изучении химического состава
хромосом. Сохраняя преемственность в ряду клеточных
поколений, хромосомы в зависимости от периода и фазы
клеточного цикла меняют свое строение.
3.
В интерфазе – это хроматин, сложный комплекс,содержащий ДНК, ядерные белки, РНК, липиды. Эта
структура, являющаяся по сути интерфазными,
активно работающими хромосомами, имеет такое
название, т.к. хорошо окрашивается основными
красителями. В метафазе митоза – это хромосомы.
Интерфазную и метафазную формы существования
хромосом расценивают как два варианта их
структурной организации.
4.
ХРОМАТИНХРОМОСОМА
5.
ХРОМАТИНЭухроматин –
Деспирализованный
Активный
Транскрибируемый
Менее окрашенный
Функции гетерохроматина:
I. Регуляция активности генов
II. Сохранение структуры
генов
Конституционный
- Теломеры
- Центромеры
Гетерохроматин Спирализованный
Конденсированный
Неактивный
Нетранскрибируемый
Более окрашенный
Факультативный
- Тельце Барра
6.
СТРУКТУРНЫЕ УРОВНИНАСЛЕДСТВЕННОГО МАТЕРИАЛА
Генный
Хромосомный
Геномный
7.
По мере усложнения от молекулярного до хромосомноговыделены уровни:
1. Двойной спирали ДНК соответствует толщина в 2 нм.
Двойная спираль может быть разной формы: обычно
встречается
правозакрученная
В
спираль,
реже
левозакрученная Z спираль.
Форма двойной спирали влияет на возможность узнавания
регуляторными белками нуклеотидных последовательностей
ДНК.
8.
Строение хромосомы на микроскопическом,субмикроскопическом и молекулярном уровнях
метафазная хромосома
пучок фибрилл толщиной 10 нм
10 нм
элементарные хромосомные нити
толщиной 10 нм (типичные для
соматических клеток)
элементарные хромосомные нити
толщиной 4 нм (типичные для ядер
4 нм спермиев)
? ДНК-гистон
негистоновый
протеин
молекулярная организация
элементарной нити
9.
2.Толщина в 11 нм соответствуетнуклеосоме, которая содержит нить ДНК
в 146-200 пар нуклеотидов (п.н.),
обернутую вокруг 8 молекул гистонов (по
паре молекул Н2А, Н2В, Н3, Н4).
Отрезок
ДНК
между
нуклеосомами
называется линкерным участком и имеет
протяженность более 50 п.н.
Молекулы гистонов взаимно удерживаются
электростатическими зарядами, поэтому их
химические
модификации
(фосфорилирование,
ацетилирование)
приводят к изменению зарядов и распаду
нуклеосом,
в
результате
чего
заблокированный ранее участок ДНК
становится открытым для транскрипции.
10.
НУКЛЕОСОМАГистоны Н2А, Н2В, Н3, Н4.
Коровая частица
ДНК
Линкерная ДНК
НУКЛЕОМЕР
Гистон Н1
Гистоны Н2А, Н2В, Н3, Н4.
ДНК
11.
Хроматиновая фибрилла d 20-30 нм3.Нуклеосомной (хроматиновой)
фибрилле
соответствует
толщина
30
нм.
В
ее
формировании участвуют гистон
Н1 и негистоновые белки.
Среди последних известны белки
HMG14 и HMG19, способные к
связыванию с нуклеосомой в
строго определенном месте.
На
этом
уровне
упаковки
регулирование
транскрипции
связывают с действием комплекса
гормона-рецептора
на
нуклеосомную
фибриллу,
освобождающим участки ДНК
(активирующим
определенные
гены).
Нуклеомер
("соленоид")
Нуклеосомная
фибрилла
Соединение нуклеосом с помощью
гистона Н1
12.
4. Толщина в 300 нм соответствуетпетлевидным структурам фибриллы доменахромонеме (нуклеонеме).
Фибриллы
имеют
связи
(возможно
специфические) с белками хромосомного
каркаса, ядерного матрикса и белками
внутренней части ядерной мембраны.
13.
5. Толщина в 700 нм соответствует отдельнымхроматидам,
кондесирующимся в
митозе. Для
сближения фибрилл существенную роль играют ионы
Са2+ и Mg2+. В хроматиде помимо компонентов
нуклеосомных фибрилл участвует белковый матрикс
(остов) хроматиды
14.
Петельнаяструктура
интерфазная хромонема
6. Метафазная хромосома достигает толщины
1400 нм или 1,4 мкм, содержит две хроматиды,
объединенные первичной перетяжкой.
Под электронным микроскопом хромосома
выглядит как сложное переплетение 20-80
фибрилл (каждая толщиной 30 нм) вокруг
белкового каркаса (содержащего негистоновые
белки, гистоны, ламины, топоизомеразу).
Белковый каркас воспроизводит форму
хромосомы.
В ней имеются участки теломерные,
центромерные, множество участков начала
репликации и транскрипции.
хроматина
–
15.
Денверскаяразличает хромосомы по
величине
(А-крупные,
С-мелкие)
и
расположению центромер (метацентрические,
субметацентрические и акроцентрические, у
которых центромер находится на одном из
концов хромосом). Согласно рекомендациям
этих конференций, хромосомы располагаются
в порядке уменьшения их длины от 1 до 23п
хромосом. Они разделены на 7 групп, которые
обозначены буквами английского алфавита от
А до G.
16. По Парижской классификации (1970) используют процедуру окраски, выявляющую поперечные полосы, 2 плеча хромосомы обозначены как
q – длинноеплечо и p – короткое плечо. Поперечные
полосы удается выявить, если перед
окраской обработать хромосомы трипсином.
Выделяют
разные
типы
сегментов
(обозначают по методам) - Q-сегменты, Gсегменты, Т-сегменты, S-сегменты. Каждая
хромосома
человека
содержит
свойственную
только
ей
последовательность полос, что позволяет
идентифицировать каждую хромосому.
17.
На метафазной хромосоме приводятсясимволы, которыми принято обозначать
короткое и длинное плечо, а также
расположение районов и сегментов.
18.
Кариотип женщиныКариотип мужчины
19.
Система записи кариотипов46, XX — нормальный кариотип (женщина)
46, XY — нормальный кариотип (мужчина)
45, XО — синдром Шерешевского-Тернера
47XXY,48 xxxY — синдром Клайнфельтера
47, XXX — синдром «трисомии по Ххромосоме»
47, XX, + 21 — синдром Дауна (женщина)
47, XY, + 21 — синдром Дауна (мужчина)
47, XX, + 18 — синдром Эдвардса (женщина)
47, XY, + 18 — синдром Эдвардса (мужчина)
47, XX, + 13 — синдром Патау (женщина)
47, XY, + 13 — синдром Патау (мужчина)
46, XY, t (15/21) — транслокационный с.Дауна
(мужчина)
20.
Тельцеполовой хроматин
Барра-
Основные гипотезы теории М.
Лайон следующие:
1.Одна из 2 Х- хромосом клеток
женщины неактивна.
2.Неактивная хромосома может
быть
отцовского
или
материнского организма.
3. Инактивация происходит в
раннем
эмбриогенезе
и
сохраняется
во
время
дальнейшего размножения и
развития клеточной линии. Этот
процесс
инактивации
Ххромосомы в ряду поколений
обратим.
Тельце Барра обнаруживается при
хромосомном
наборе
46, ХХ
(нормальные женщины);
47, ХХУ и 48, ХХУУ ( синдром
Клайнфельтера)
21.
В клетках мужчин (кариотип 46, XY) Х-хромосома всегдавыполняет активную функцию, а у женщин (46, XX) одна Ххромосома является активной, а другая Х-хромосома находится
в неактивном, спирализованном состоянии. Она выявляется в
виде компактной темной глыбки в интерфазном ядре
соматических клеток нормальных женщин и называется тельцем
Барра или половым Х-хроматином.
Инактивация одной из двух Х-хромосом происходит в
эмбриогенезе, причем закономерности в инактивации отцовской
или материнской хромосомы нет (гипотеза Лайон).
При любом числе Х-хромосом в активном состоянии будет
только одна, следовательно, половой Х-хроматин в норме
выявляется только у женщин и отсутствует у мужчин.
22.
Зная число глыбок полового хроматина, можноопределить число Х-хромосом по формуле:
п + 1, где п — число глыбок, а 1 — активная Ххромосома;
и наоборот, зная число Х-хромосом, можно
определить число телец Барра по формуле:
п -1, где п — число Х-хромосом, а 1—активная Ххромосома.
23.
Наследственная теория Т. МорганаХромосомная теория наследственности
— теория, согласно которой хромосомы,
заключённые в ядре клетки, являются
носителями генов и представляют собой
материальную основу наследственности,
то
есть
преемственность
свойств
организмов
в
ряду
поколений
определяется
преемственностью
их
хромосом.
24.
• Каждый ген имеет в хромосоме определённыйлокус.
• Гены в хромосоме расположены линейно в
определённой последовательности.
• Гены одной хромосомы сцеплены, поэтому
наследуются преимущественно вместе.
• Частота кроссинговера между генами равна
расстоянию между ними.
25.
Основные положения хромосомной теориинаследственности:
1. Гены локализованы в хромосомах. При
этом различные хромосомы содержат
неодинаковое число генов. Кроме того,
набор генов каждой из негомологичных
хромосом уникален.
2. Аллельные гены занимают одинаковые
локусы в гомологичных хромосомах.
3. Гены расположены в хромосоме в
линейной последовательности.
26.
4. Гены одной хромосомы образуют группу сцепления, тоесть наследуются преимущественно сцепленно (совместно),
благодаря чему происходит сцепленное наследование
некоторых признаков. Число групп сцепления равно
гаплоидному
числу
хромосом
данного
вида
(у
гомогаметного пола) или больше на 1 (у гетерогаметного
пола).
5. Сцепление нарушается в результате кроссинговера,
частота которого прямо пропорциональна расстоянию
между генами в хромосоме (поэтому сила сцепления
находится в обратной зависимости от расстояния между
генами).
6.
Каждый
биологический
вид
характеризуется
определенным набором хромосом — кариотипом.
27.
КроссинговерБыло установлено, что кроме обычных
(некроссоверных) гамет возникают и
другие (кроссоверные) гаметы с новыми
комбинациями генов— Ab и аВ,
отличающимися от комбинаций генов в
хромосомах родителя.
Причиной возникновения таких гамет
является
обмен
участками
гомологичных
хромосом,
или
кроссинговер.
Кроссинговер происходит в профазе I
мейоза
во
время
конъюгации
гомологичных хромосом. В это время
части
двух
хромосом
могут
перекрещиваться и обмениваться своими
участками.
28.
В результате возникают качественно новыехромосомы, содержащие участки (гены) как
материнских, так и отцовских хромосом.
Особи, которые получаются из таких гамет с
новым
сочетанием
аллелей,
получили
название
кроссинговерных
или
рекомбинантных.
Частота (процент) перекреста между двумя
генами, расположенными в одной хромосоме,
пропорциональна расстоянию между ними.
Кроссинговер между двумя генами происходит
тем реже, чем ближе друг к другу они
расположены.
29.
Кроссинговер :• Митотический
• Мейотический
Митотический
кроссинговер может
происходить между
двумя несестринскими
хроматидами на стадии;
возможен и в половых
хромосомах, и в
аутосомах.
30.
Мейотический кроссинговер –генетически обусловленный процесс. У большинства
организмов кроссинговер характерен как для самок, так и
для самцов, но у некоторых (например, дрозофилы) он
происходит только у гомогаметного пола (самок).
Важнейший механизм, обеспечивающий комбинативную
изменчивость в популяциях и тем самым дающий материал
для естественного отбора. Может приводить к
перекомбинации больших участков хромосомы с
несколькими генами или частей одного гена, обеих нитей
молекулы ДНК или только одной. Процесс кроссинговера
ведет
к
внутрихромосомным
рекомбинациям
наследственности.
31.
В зависимости от количества появившихся хиазм:- Одиночный кроссинговер – образуется только одна
хиазма, что ведет к обмену только одним участком ДНК
гомологичных хромосом. Это наиболее распространенный
тип кроссинговера.
- Двойной кроссинговер - образуются две хиазма. Они
могут появляться как между одними и теми же
несестринскими хроматидами, так и между разными
несестринскими хроматидами. Этот тип кроссинговера
приводит к обмену двумя участками ДНК гомологичных
хромосом.
- Множественный кроссинговер – образуется более двух
хиазм между несестринскими хроматидами гомологичных
хромосом. Далее они могут быть классифицированы как
тройные ( 3 хиазмы), четвертные ( 4 хиазмы)
32.
Биологическое значение кроссинговера чрезвычайновелико,
поскольку
генетическая
рекомбинация
позволяет создавать новые, ранее не существовавшие
комбинации генов и тем самым повышать
наследственную изменчивость, которая дает широкие
возможности адаптации организма в различных
условиях среды.
33.
Генетические картыГенетическая карта — это схема
взаимного
расположения
и
относительных
расстояний
между генами определённых
хромосом, находящихся в одной
группе сцепления.
Она представляет собой отрезок
прямой, на котором нанесён
порядок расположения генов
и указано расстояние между
ними в морганидах.
Генетические карты хромосом
составлены для многих видов
организмов.

Биология
Биология








